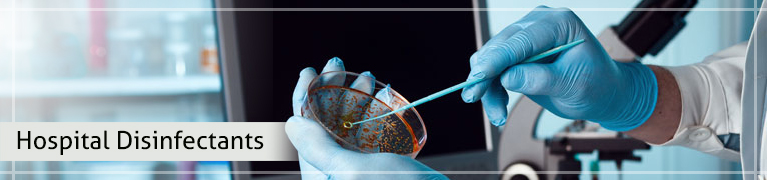

HOSPITAL DISINFECTANTS
(Manufactured by Radix Hi-Care Products, Roorkee)
Leading The Way in Disinfection and Environmentally Friendly Solutions
ACURO's makes a variety of hospital-grade disinfectants and sanitizers for use in healthcare, schools, offices, daycares, restaurants and more. A big part of infection control is sanitation practices that include regular cleaning and disinfecting, in particular, high-touch surfaces contacted by many individuals over a short period.
CERTIFICATIONS :
- Drug License
- ISO 9001
- FDA
- GLP (Good Laboratory Practise)
- WHO-GMP
Acuro Organics Limited
Corporate office:
B-19, Sector-1, Noida-201301, UP, INDIA
TEL: +91-120-4888444 (100 lines)
Registered office:
DSM 446 & 447, DLF Corporate Tower,
Shivaji Marg, New Delhi-110015, INDIA